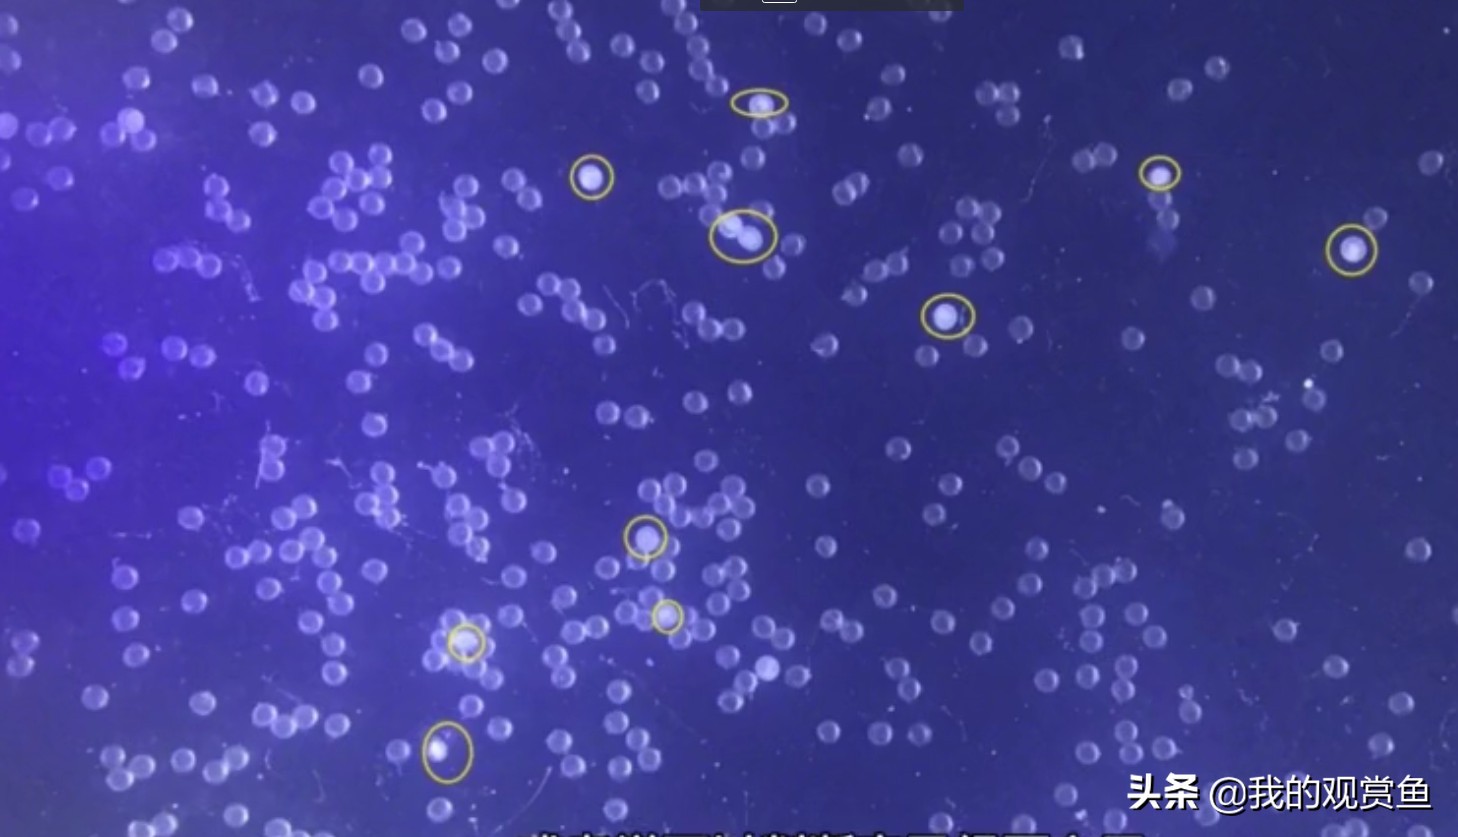
金鱼甩卵怎么孵化小鱼,金鱼打籽几天能孵化

金鱼,在我国是一种吉祥的象征。现在越来越多的人养殖金鱼。
也有很多的鱼友。自己在家里进行繁殖金鱼。繁殖金鱼并把他们带大,对于养鱼的人来说充满了成就感。这个过程虽然有点儿辛苦。但是最后有收获的。
金鱼繁殖种鱼的选择。一般我们自己在家里繁殖金鱼呢,不一定会进行特定的选择种鱼。当然,好的种鱼繁殖出来的鱼苗呢,肯定会给你带来惊喜。尽量选择自己比较喜欢和健康的金鱼做种鱼。但我们不是专业的,。所以对种鱼没有太高的要求。

有特点的金鱼可以做种鱼
一 人工辅助受精
金鱼发情一般在凌晨4:00.到上午的时间,现在的金鱼一般采用人工授精,这样的话受精率会高一点。需要手动辅助他们进行甩籽和受精。我们需要一手拿一条公鱼一手拿一条母鱼。把两条鱼握着大拇指按在鱼的屁股上面的肚子。然后两条鱼的屁股对着屁股轻轻用大拇指按压就行了,切记不要太用力按压,成熟的金鱼只需要一点点力量卵子和精子就会出来。一边按母鱼的肚子一边按公鱼的肚子。用金鱼的尾巴或者用手在水里搅拌一下,防止这个鱼卵黏在在一起,把鱼卵打散。这样可以提高受精率。
视频加载中...
二 水质管理和鱼卵的管理
打卵受精完成之后,我们就只需要耐心等待了,挤出鱼卵的容器让它静止就好大概在6到10个小时左右,我们需要把容器里面的水给换掉,换新水的目的是因为公鱼的精子在容器里很容易坏水。换水的时候一定要等温,不能和容器面的水 温差太大。孵化期间只需要换这一次水就行了。接下来的时间需要观察鱼卵的受精情况,发现没有成功受精的鱼卵要及时挑出来(可以使用小的吸管),不然没有受精的鱼卵会长毛,滋生细菌,导致水的变质。成功受精的鱼卵透亮或者发黄,没有受精成功的鱼卵呈白色。
圈出来的就是没有受精的鱼卵
三 温度控制
孵化时间由温度决定,温度高孵化时间短但是畸形率高,合适的温度孵化时间长但是畸形率低,温度高大哥2-3天就出壳了。温度低大概时间也就3-5天左右。温度一般不能低于18度,温度最好控制在20-22度之间。
四 鱼苗出壳 挂丁 平游 喂食
第三天到第四天鱼苗开始陆陆续续出壳了,这个时候的鱼苗还是不能去管它,我们要做的依然是静静的等待,一般在容器的底部,偶尔游动一下。

鱼苗刚刚出壳
等到第二天基本都出壳了。他们会陆陆续续的游动,最后能看到缸壁上面密密麻麻的鱼苗挂在上面,这个就是鱼苗的“挂丁”。这个时候也不要管它也不用喂食,如果密度不大,可以不要打氧。

挂丁
等到鱼苗已经能陆陆续续出自己游动了,这时候我们称为(起飞)平游,我们可以选择给它们喂食了,也可以选择不喂,鱼苗自带的卵黄够它们维持两三天。如果喂食这个时候有条件的可以选择刚孵化出来的丰年虾喂食,也可以喂食煮熟的鸡蛋黄弄碎使用蛋黄水喂养,不管是丰年虾还是蛋黄水,一定记得少量多餐,因为鱼苗很小,他们吃的很少,喂食过多,鱼苗吃不完容易引坏水。

给平游后的鱼苗进行喂食